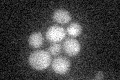
YML083C
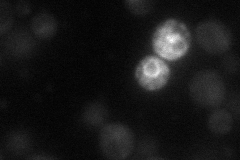
YML083C
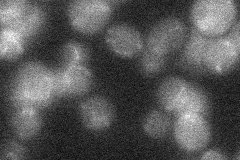
YML083C

View description
Putative protein of unknown function; strong increase in transcript abundance during anaerobic growth compared to aerobic growth; cells deleted for YML083C do not exhibit growth defects in anerobic or anaerobic conditions
Localization:
Intensity:
Fold change:
Significance:
-
C’ GFP library in SD
below threshold18.64 -
N' NOP1pr-GFP in SD
nucleus26.5925 -
N' TEF2pr-mCherry in SD

ambiguous5.44272 -
N' NATIVEpr-GFP in SD
below threshold18.8502 -
N' TEF2pr-VC and Cyto-VN in SD

#N/A0 -
C’ GFP library in SD+DTT

cytosol14.640.78No -
C’ GFP library in SD+H2O2

cytosol16.650.89No -
C’ GFP library in Starvation Media

cytosol15.220.81No -
C’ GFP library on the background of Pup2-DaMP

below threshold -
C’ GFP library on the background of CCT mutant

below threshold18.8881.01251No
